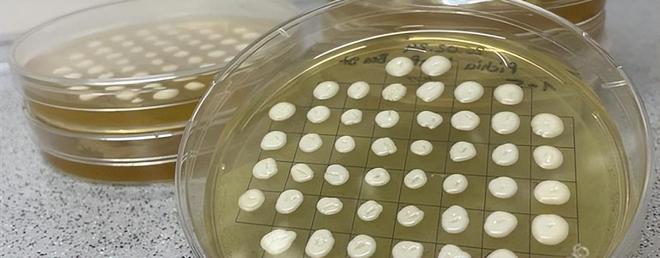
开云电竞入口:新原料资讯量子高科首款HMOs（2-FL）获卫健委批准等(图3)

量子高科旗下母乳低聚糖(以下简称HMOs)2’-岩藻糖基乳糖(以下简称2’-FL),正式获得国家卫生健康委员会(2024年6号公告)批准为食品营养强化剂,可用于婴儿配方食品、较大婴儿、幼儿配方食品、特殊医学用途婴儿配方食品和调制乳粉(仅限儿童用乳粉)的开发。这是量子高科HMOs系列中的首个获批产品,标志着企业深入践行的精准化益生元发展战略迈向新征程。
据介绍,作为益生元产业龙头,量子高科是国内较早进入HMOs领域的企业,并专注本土化人群研究。通过对不同泌乳期的中国妈妈母乳HMOs成分变化,岩藻糖基化HMOs的人群差异以及HMOs与Lewis血型关系,揭示了更多关于HMOs中所携带的母体对幼体保护和营养的生物密码和调控信息,该项目多项研究成果已在国内外期刊发表。
接下来,量子高科将借助泰莱(Tate & Lyle)集团优势资源,加快HMOs系列化产品的开发与商业布局,旨在为中国宝宝提供更丰富的生命早期营养解决方案,推动中国婴幼儿市场的高质量发展。(资讯来源:量子高科益生元微信公众号)!

美国食品药品监督管理局(FDA)发布了“健康”营养成分声明的最新标准。该规定更新了对特定营养素的限制,并明确了符合膳食指南的特定食品类别。例如,若要使用“健康”声明,产品必须限制饱和脂肪、钠和添加糖的含量。此外,产品应包含一定量来自膳食指南所推荐的食品组或亚组之一,包括但不限于水果、蔬菜、无脂和低脂乳制品等。
此前,以坚果、富含脂肪的鱼类如鲑鱼以及油脂和水分等食物为基础的健康饮食模式并不符合“健康”标签的标准。如今,根据最新的规定,这些食品现已被认定为符合“健康”营养成分声明的要求,花生酱、水果罐头和蔬菜等食品亦可能满足条件。FDA指出,选择采用该声明的制造商将有三年时间以符合新标准,但制造商可以选择提前遵循新规定。(资讯来源:Nutritional Outlook)!

图源:public-inspection.federalregister.gov?
3、研究人员开发一种基于植物蛋白质来源甜味剂,其甜度为糖的10,000 倍!
在名为NovelSweets的联合研究项目中,德国弗劳恩霍夫分子生物学和应用生态学研究所(IME)携手MetaX Institut für Diätetik 和 Candidum ,成功研发出一种植物甜味蛋白,其甜度约为糖的10,000倍。该成分旨在支持德国联邦食品和农业部减少市售产品和饮料中的糖分含量,应对因营养不良导致的健康问题日益增多的挑战。
据了解,甜味蛋白(SP)是自然界中某些植物和水果所含有的分子,因独特的结构特性,其能轻易地与人类味觉受体结合,类似糖的结合方式,其中最知名的甜味蛋白之一是brazzein,它是一种在非洲植物Pentadiplandra brazzeana中发现的蛋白质。由于从植物中提取蛋白质是一个“漫长而费力”的过程,NovelSweets 团队合作伙伴应用微生物发酵技术基于brazzein 的蛋白质序列开发出新品种甜味蛋白”X3”。
该团队称,X3味道与蜂蜜相似,一克的甜度相当于大约10 公斤的糖,只需几毫克的SP就能够达到相同的甜度水平,由于它完全不含糖并且“几乎没有卡路里”,因此它不会影响血糖水平或导致蛀牙。据透露,该团队的第一个计划是将替代品添加到饮料中,项目合作伙伴 MetaX 目前正在测试和开发第一批含有X3 的产品,例如用可可制成的低蛋白饮料粉。在批准流程开始之前,会进一步优化生产流程并采取进一步的产品验证措施,以便释放 X3 蛋白版本的全部潜力。(资讯来源:foodbev)!
面对气候变化对全球农业造成的日益严重的影响以及餐饮业正持续应对经济、社会以及环境等多方面的挑战,农业科技企业Lyris开发出一种多倍体杂交嫁接技术,该技术可显著提升农作物在高温环境下的耕作适应性,并大幅加速了将遗传抗逆性植入植物砧木的自然进化过程。农民可通过这项技术种植西红柿等具有抗逆性的作物,其产量相较于市场上表现最佳的同类产品平均提升了20-25%。
“数世纪以来,农民们投入了大量时间、资金和土地资源于每个作物季节,寄希望于不可控的天气条件能够保障他们农场的经济可持续性,Lyris正着手解决这一问题。”Lyris的联合创始人、沙特阿拉伯阿卜杜拉国王科技大学植物科学教授Mark Tester博士如是说。据介绍,该技术是基于Tester经过数十年对生长在加拉帕戈斯群岛面向海洋的岩壁上番茄的弹性亲缘关系的实践验证和研究成果,其可增强作物对盐碱、干旱、高温以及害虫等非生物胁迫的抵抗力,为农民提供更高的产量并降低了作物歉收的风险。
据悉,Lyris公司弹性杂交番茄技术已经推向市场,并与全球最大的两家番茄生产巨头建立了合作关系。与此同时,Lyris与Tester正在对茄子、甜瓜和南瓜等其他植物种类进行研究,这些植物有望进一步带来商业上的新成果,对全球农业可持续性产生变革性影响。(资讯来源:foodingredientsfirst)!

美国国际膳食补充剂公司(AIDP)宣布,其L-苏糖酸镁产品Magtein已在欧洲联盟(EU)获得新型食品授权。根据官方公告,该授权为AIDP及其合作伙伴公司以及授权方ThreoTech所独有,这表明自2024年11月7日起的五年内,他们将是欧盟市场中唯一合法销售L-苏糖酸镁的实体,除非有其他申请者在未参考AIDP在其新型食品申请中使用的受保护专有数据的情况下获得授权,否则这一排他性将持续有效。因此,任何希望在独家销售期内在欧盟市场销售L-苏糖酸镁的公司,都必须向ThreoTech申请许可证并从该公司采购原料。
史密夫斐尔律师事务所 (Herbert Smith Freehills) 已被聘请追究欧盟侵犯新型食品批准所授予的排他性的公司。ThreoTech首席执行官Edward Lee表示:“Magtein获得新型食品授权意味着欧盟消费者首次体验到经过临床验证的L-苏糖酸镁的独特益处。”此外,授予AIDP及其授权方ThreoTech的五年独家经营权为消费者、制造商和品牌提供了额外的保障,确保通过ThreoTech采购的L-苏糖酸镁是安全、真实且品质最高的。(资讯来源:Nutritional Outlook)?

